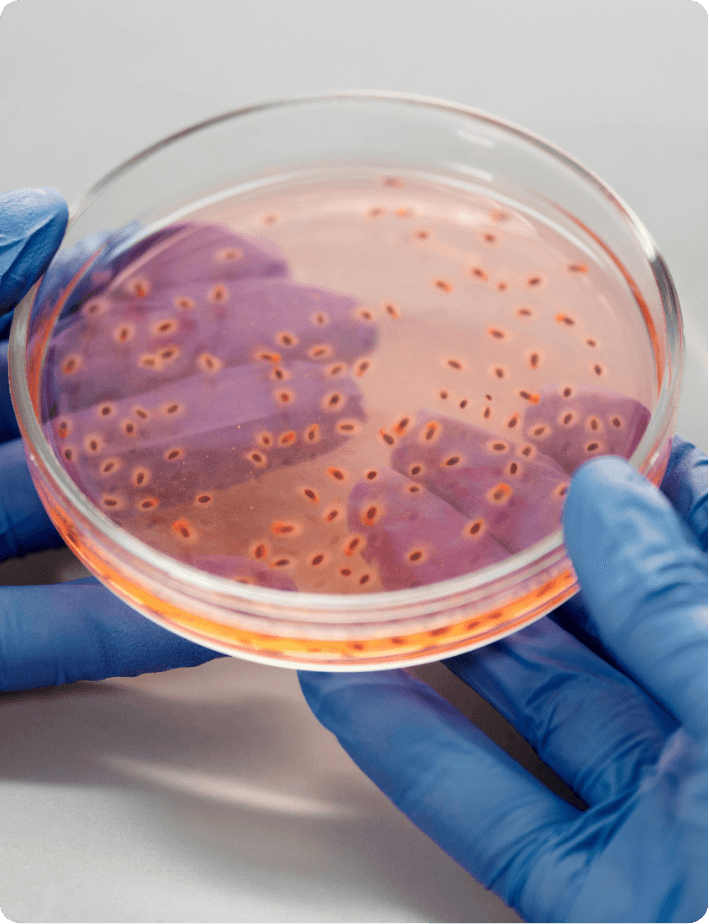

Adevărul pe care nimeni nu ți-l spune: nu te poți vindeca într-un corp infestat.



Nu poți construi o casă pe o fundație șubredă.
Te trezești obosită, deși dormi.
Mănânci corect, dar nu ai energie.
Ai pofte pe care nu le poți controla.
Te simți umflată, iritată, fără chef de viață, îți cade greu la stomac.
Și oricât încerci să te reglezi - ceva te trage înapoi.
Acel „ceva” nu e în mintea ta. Este în tine la propriu.
Este prezența a ceva ce nu-ți aparține.
Ce se întâmplă în corp

Paraziți, bacterii patogene, fungi, viruși latenți – trăiesc în corpul tău fără ca tu să știi.
Conform datelor publicate de Organizația Mondială a Sănătății (OMS) în ianuarie 2023, aproximativ una din patru persoane de pe glob este infectată cu cel puțin un tip de parazit - cifră care reflectă amploarea globală a infecțiilor parazitare menționată în raportul oficial al OMS Soil-transmitted helminth infections (WHO Fact Sheet, 18 ianuarie 2023).
Se hrănesc din nutrienții tăi, din energia ta, din vitalitatea ta, îți sabotează sistemul imunitar, îți distorsionează hormonii foamei și sațietății, îți fură energia și îți tulbură gândurile.
Iar tu, fără să-ți dai seama, le întreții viața zilnic prin stres, mâncare procesată și oboseală cronică.
Asta e realitatea de care nimeni nu vorbește - că uneori, ceea ce te consumă… chiar te consumă.
Când ei cresc, tu te stingi.
Și între timp, tu te întrebi de ce nu mai ești tu.

Am creat acest curs pentru ca tu să devii mai conștientă de adevărul pe care nimeni nu îl spune - vindecarea nu începe cu suplimente sau diete, ci cu curățarea corpului de tot ce îl epuizează. Nu poți vindeca un corp plin de reziduuri, paraziți și toxine.
Când înțelegi cum funcționează corpul tău și de ce are nevoie să fie curățat, începi să ai o altă relație cu energia, cu mâncarea și cu tine însăți. Acesta este scopul cursului - să te facă mai prezentă, mai conștientă și mai implicată în propria ta vindecare.
Este o invitație să privești sănătatea ca pe un proces activ, în care alegi să fii atentă și responsabilă pentru energia ta, să vezi ce se întâmplă în corpul tău și să faci, în sfârșit, curățenie reală.
de ce deparazitarea este primul pas real către regenerare;
cum recunoști semnele subtile ale infestării: pofta constantă de dulce;
balonarea, oboseala fără cauză, iritabilitatea inexplicabilă;
ce tipuri de paraziți, bacterii și viruși îți pot distorsiona metabolismul și starea de spirit;
de ce nu poți slăbi sau te îngrași „fără motiv”;
de ce unele stări emoționale nu sunt „ale tale”, ci rezultatul unui dezechilibru biologic profund;
cum paraziții influențează hormonii, starea de bine și gândurile tale;
ce înseamnă o curățare profundă și de ce corpul tău nu se regenerează până nu o faci;
cum se face o deparazitare cu rezultate reale.
Acest curs nu este despre detox de weekend sau despre sucuri verzi…
Este despre a-ți lua înapoi controlul asupra corpului tău.
Completează formularul și primești instant acces la toate lecțiile.

E un proces de conștientizare. Un moment în care alegi să nu mai trăiești în orb. Să nu mai „te adaptezi” la o stare care nu e normală. Corpul tău așteaptă să-l cureți, să-i redai vitalitatea, claritatea, forța.
Dacă ai simțit de ceva timp că „nu mai ești tu”, dacă ai oboseală care nu se explică, pofte care nu cedează, un corp care pare că nu te mai ascultă - nu amâna.
Fă curățenie. Redu la tăcere tot ce ți-a furat energia. Recuperează-ți corpul. Cursul „Deparazitarea - primul pas în vindecare” te ajută să înțelegi aspecte mai profunde ale vindecării.
Să vezi legătura dintre paraziți, oboseală, pofte, inflamații și confuzia mentală. Să-ți recapeți capacitatea naturală de regenerare a corpului.
Este cursul care îți arată ce se întâmplă în corpul tău atunci când nu mai știi de ce ești epuizat, agitat sau blocat. Și te ajută să înțelegi de unde începe, cu adevărat, sănătatea.
Începe acum cursul și descoperă ce te consumă din interior.
Metabolismul se reașează.
Corpul începe să folosească energia corect, iar senzația de epuizare constantă se diminuează treptat.
Digestia se liniștește.
Balonarea, greutatea după masă și disconfortul abdominal se reduc pe măsură ce tractul digestiv se eliberează de încărcare.
Somnul devine odihnitor.
Adormi mai ușor, te trezești cu mintea limpede și simți că organismul s-a refăcut peste noapte.
Poftele se reduc treptat.
Corpul nu mai cere compulsiv dulce, făinoase sau gustări, pentru că dispare stimularea artificială produsă de dezechilibrele interne.
Inflamațiile scad.
Pielea se limpezește, durerile difuze se atenuează și corpul capătă un tonus natural și stabil.
Mintea se clarifică.
Gândurile devin mai ordonate, reacțiile emoționale se temperează și apare o senzație de „ușurare mentală”.
Sistemul imunitar se reface.
Corpul devine mai rezistent la infecții și răspunde mai rapid în perioadele de stres sau oboseală.
Apare o stare de vitalitate profundă.
Nu e energie de moment, ci un flux stabil care curge firesc din interior, fără stimulente externe.
Hormonii revin la echilibru natural.
Foamea, sațietatea, energia și starea de spirit încetează să mai fie influențate de dezechilibre ascunse, iar corpul își recapătă ritmul firesc.

Ai văzut ce se întâmplă în corpul tău atunci când îl lași să fie copleșit de toxine, paraziți și dezechilibre invizibile.
Ai recunoscut poate unele dintre simptome, te-ai regăsit în fragmentele de oboseală, de confuzie, de pofte pe care nu le poți controla.
Acum e momentul să nu mai amâni.
Dă-ți șansa să înțelegi cu adevărat ce îți consumă energia și cum îți poți recupera corpul, claritatea și vitalitatea.
Cursul acesta îți oferă exact cunoașterea de care ai nevoie pentru a porni pe drumul corect - un drum al curățării, al echilibrului și al revenirii la tine.
Companie
SC NOVA CONSULT EXPERIENCE SRL
25785219
J2009007965406
Mogosoaia, Str. Stadionului, nr. 2, Jud. Ilfov